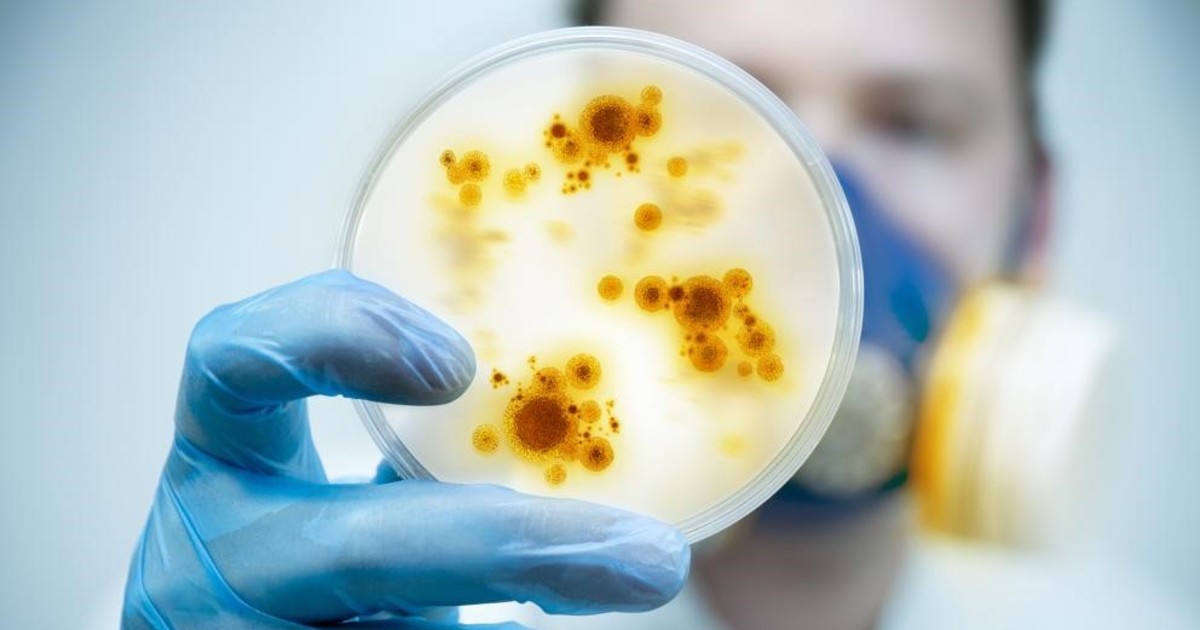

Generales Escuchar artículo
"Le pegaron un tiro a Bastián": el dramático relato de los testigos que asistieron al nene de 10 años asesinado por un policía
Vecinos y allegados al club donde jugaba Bastián Escalante declararon en la segunda jornada del debate.Se espera que la mamá de la víctima declare este miércoles. Luego serán los alegatos y el ve...
Vecinos y allegados al club donde jugaba Bastián Escalante declararon en la segunda jornada del debate.Se espera que la mamá de la víctima declare este miércoles. Luego serán los alegatos y el veredicto.